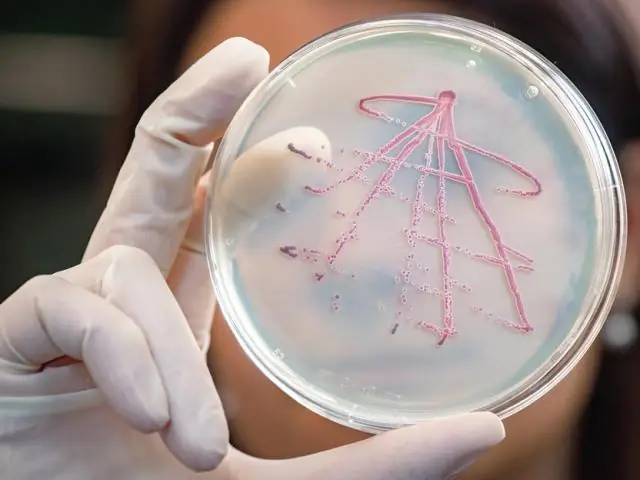
Выживание: для бактерий соседи совместно определяют, какая клетка умирает первой

Бактерии не просто случайно погибают в фазах голода; скорее, окружающие клетки также имеют право голоса. Исследовательская группа из Мюнхенского технического университета (TUM) обнаружила, что жизнь и смерть решают прежде всего два фактора: энергия, необходимая для продолжения жизни, и эффективность, с которой выжившие клетки могут перерабатывать биомассу из мертвых клеток.
Выживание и рост клеток являются центральными факторами в биологических системах. Поэтому такие ученые, как Ульрих Герланд, профессор физики сложных биосистем в ТУМ, пытаются понять, как взаимодействуют молекулярные компоненты, чтобы поддерживать жизнеспособность группы клеток в стрессовых ситуациях.
Команде под руководством Ульриха Герланда удалось определить два важнейших фактора выживания бактерии: основное потребление энергии клеткой и количество энергии, которое выжившие клетки могут получить на соседнюю мертвую клетку, измеряя эффективность переработки биомассы.
Питательные вещества из соседних клеток трупов
Исследователи сымитировали чрезвычайную ситуацию в клетках бактерии Escherichia Coli, в которой бактериям не хватало сахара и других углеводов. Таким образом, у бактерий не было ни энергии, ни строительных материалов.
По мере того, как умирали первые клетки, выжившие клетки пытались получить питательные вещества из окружающих их клеточных трупов. Чем выше был энергетический оборот определенного фермента, тем больше была смертность. Чем больше они смогли переработать из мертвых клеток, тем выше была скорость выживания.
«Наши результаты впервые позволяют количественно определить вклад отдельных молекулярных компонентов в выживание бактериальных клеток», - говорит Герланд.
Упадок жизнеспособности как коллективное явление
В целом, количество выживших клеток со временем уменьшалось в геометрической прогрессии. В принципе такое развитие можно объяснить случайной гибелью отдельных клеток, как и при радиоактивном распаде, который также имеет экспоненциальную кинетику.
Но взаимосвязи более сложны, как выяснили исследователи, меняя экспериментальные условия. Распад бактериальных колоний является коллективным явлением. Таким образом, окружающие бактериальные клетки совместно определяют, погибнет или выживет клетка среди них.
Математический анализ выживания
Изменения уровня смертности могут быть вызваны множеством генетических или экологических нарушений, влияющих на выживание бактерий. Таким образом, возникающий баланс различен для каждой бактерии и каждого условия окружающей среды.
Чтобы понять динамику, исследователи математически смоделировали общую систему выживания бактерий. Затем они использовали эту взаимосвязь для определения молекулярного вклада в выживание клеток.
В зависимости от типа клеток могут быть идентифицированы важные молекулярные факторы для выживания клеток, и это облегчает открытие ферментов или других белков, определяющих скорость выживания.
«Наша цель - систематически и количественно понять, как бактериям удается выживать во многих условиях окружающей среды», - говорит Герланд. «Это поиск физиологии выживания».